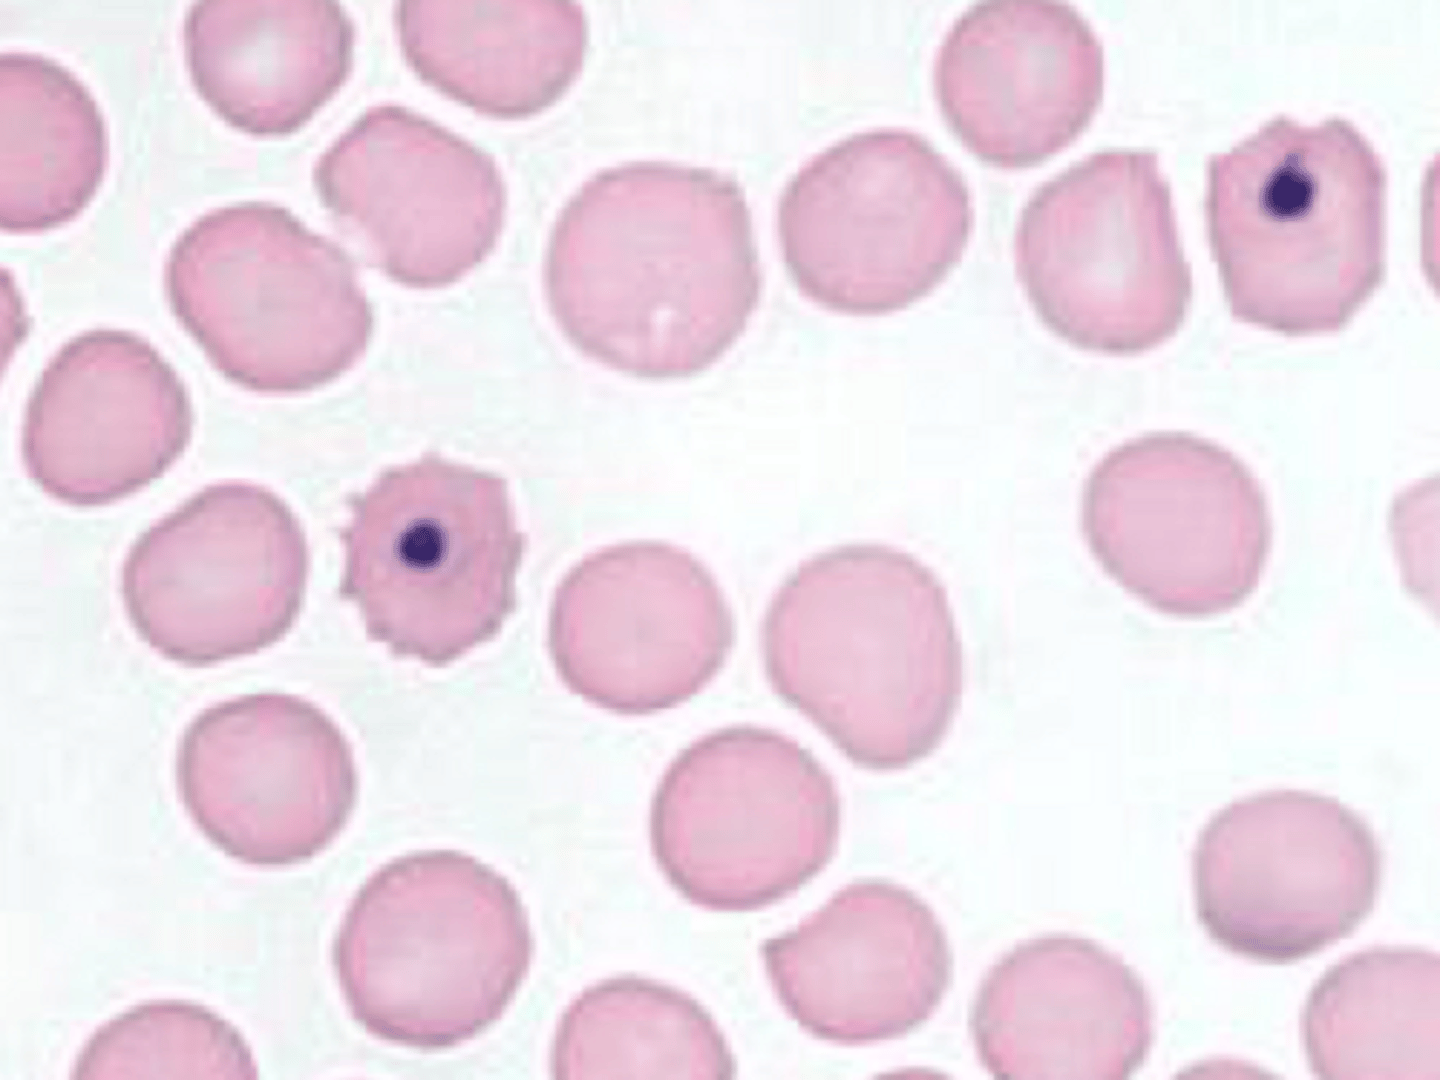
<p>What is a Howell jolly body?</p>
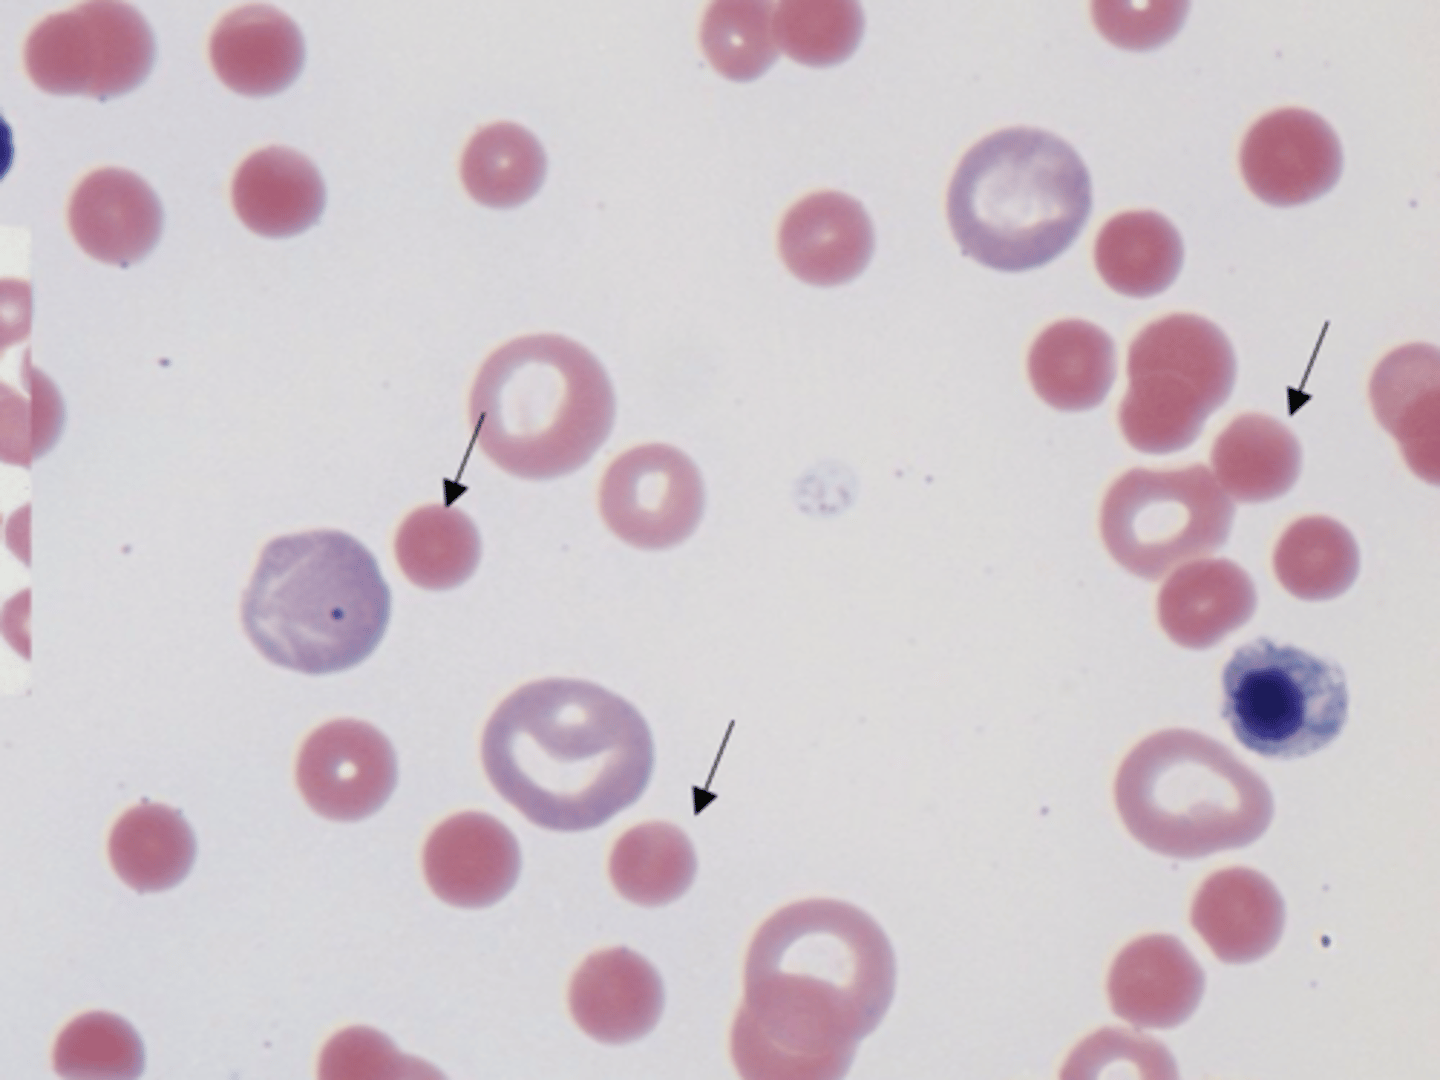
<p>What are the following cells?</p>
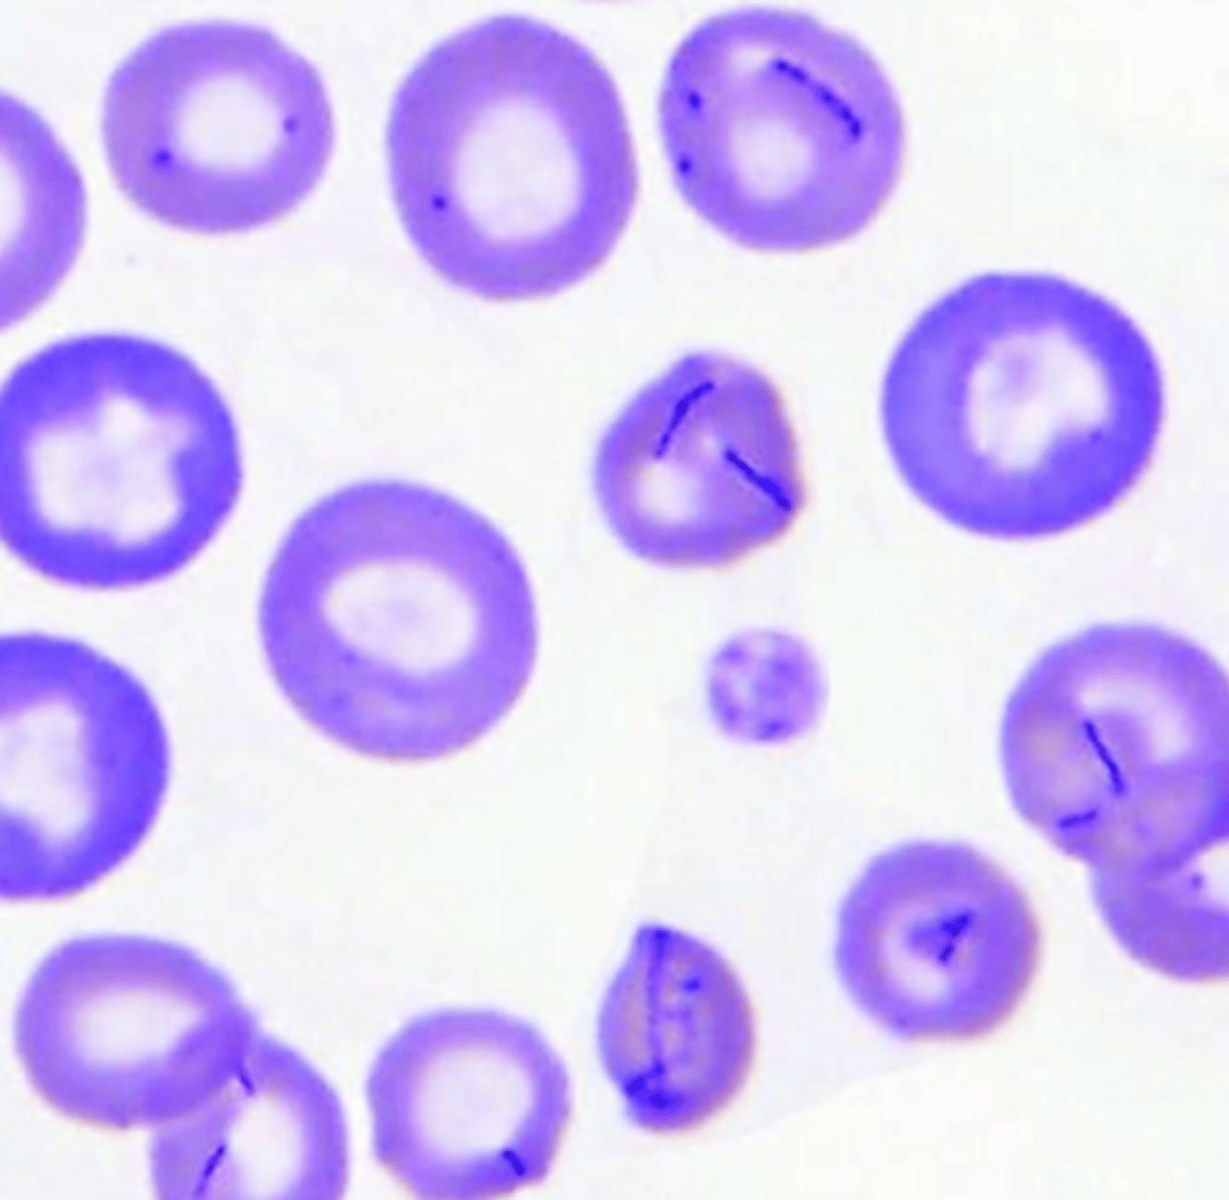
<p>Mycoplasma haemofelis will cause what? </p>
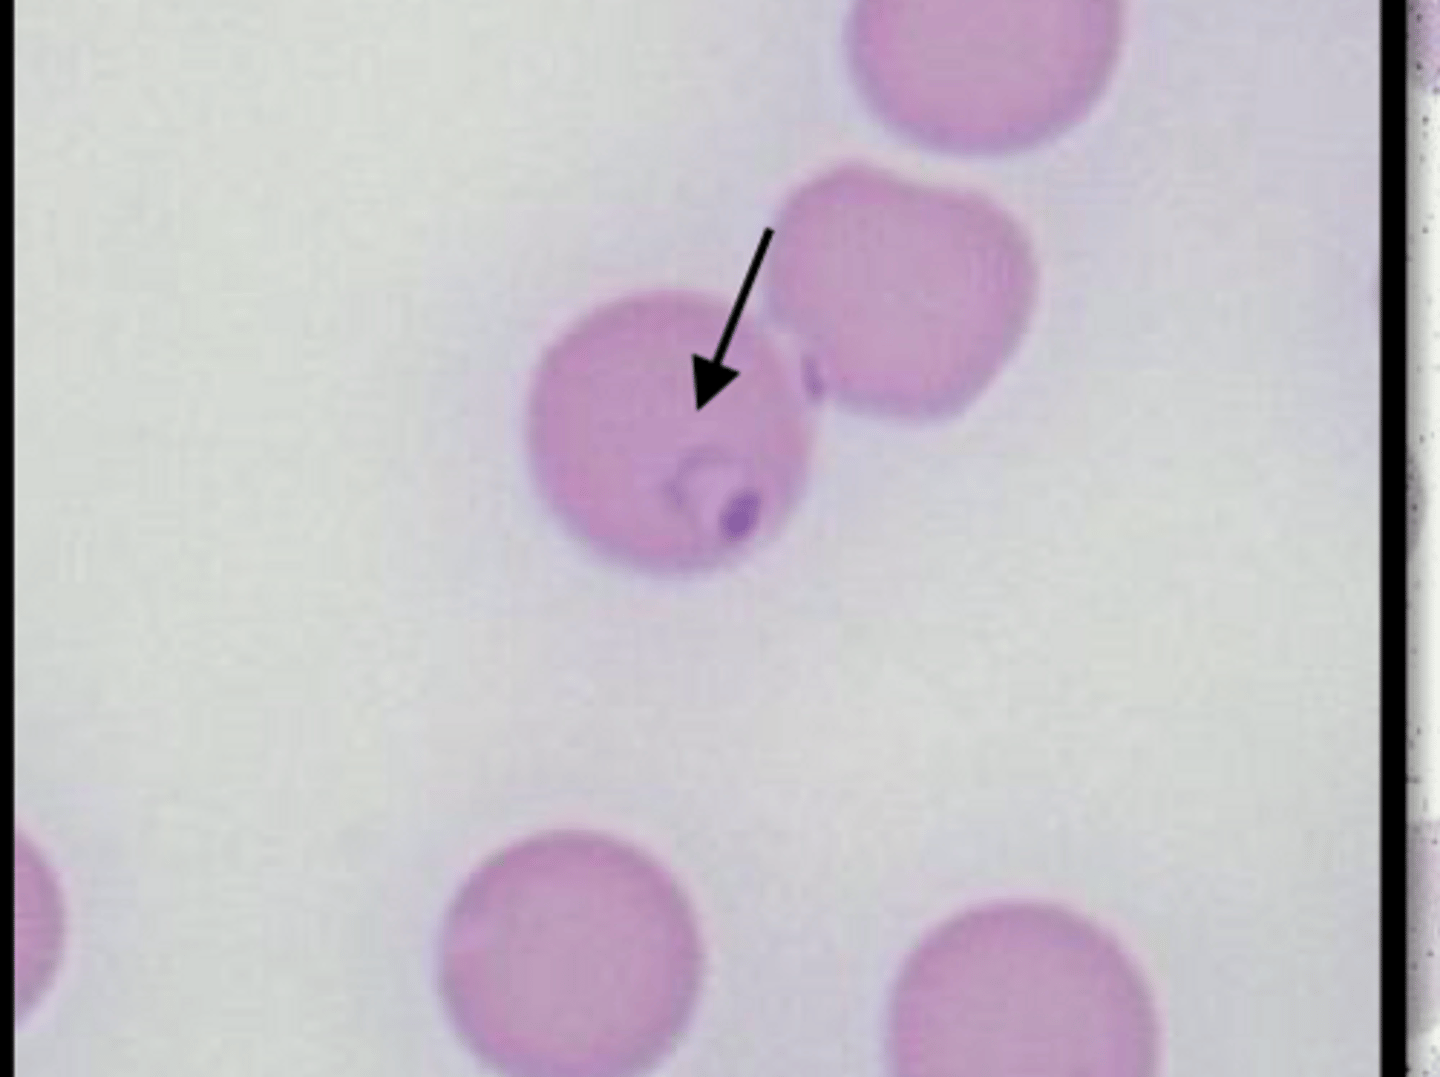
<p>What will Cytauxzoon felis cause? </p>
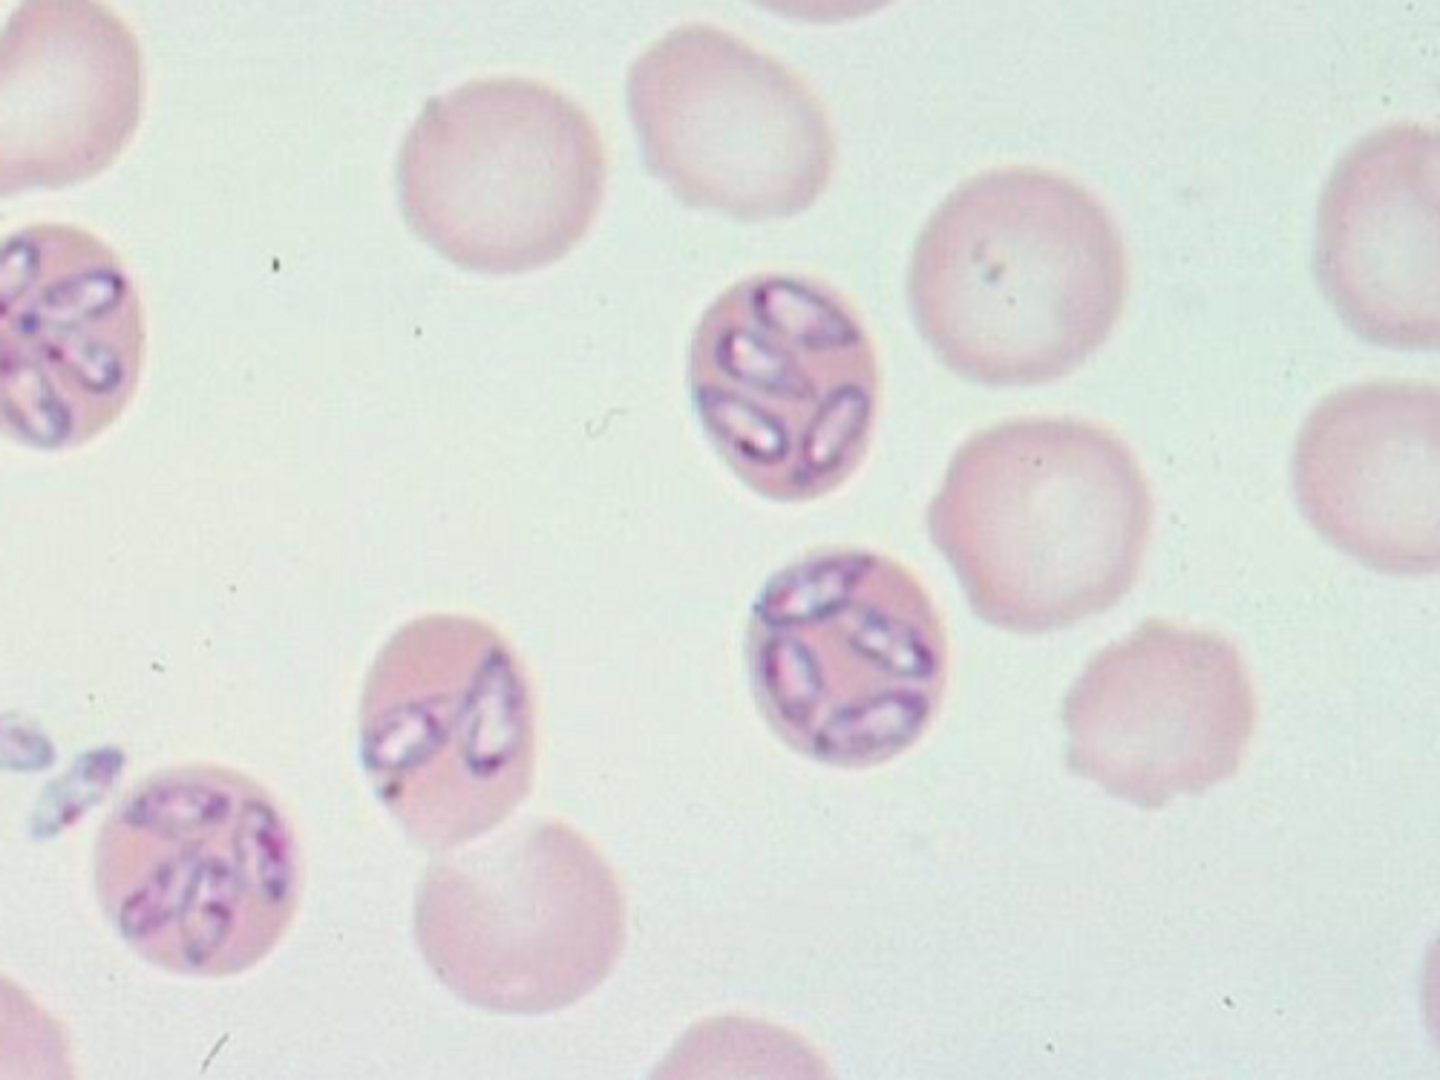
<p>What is the following parasite?</p>
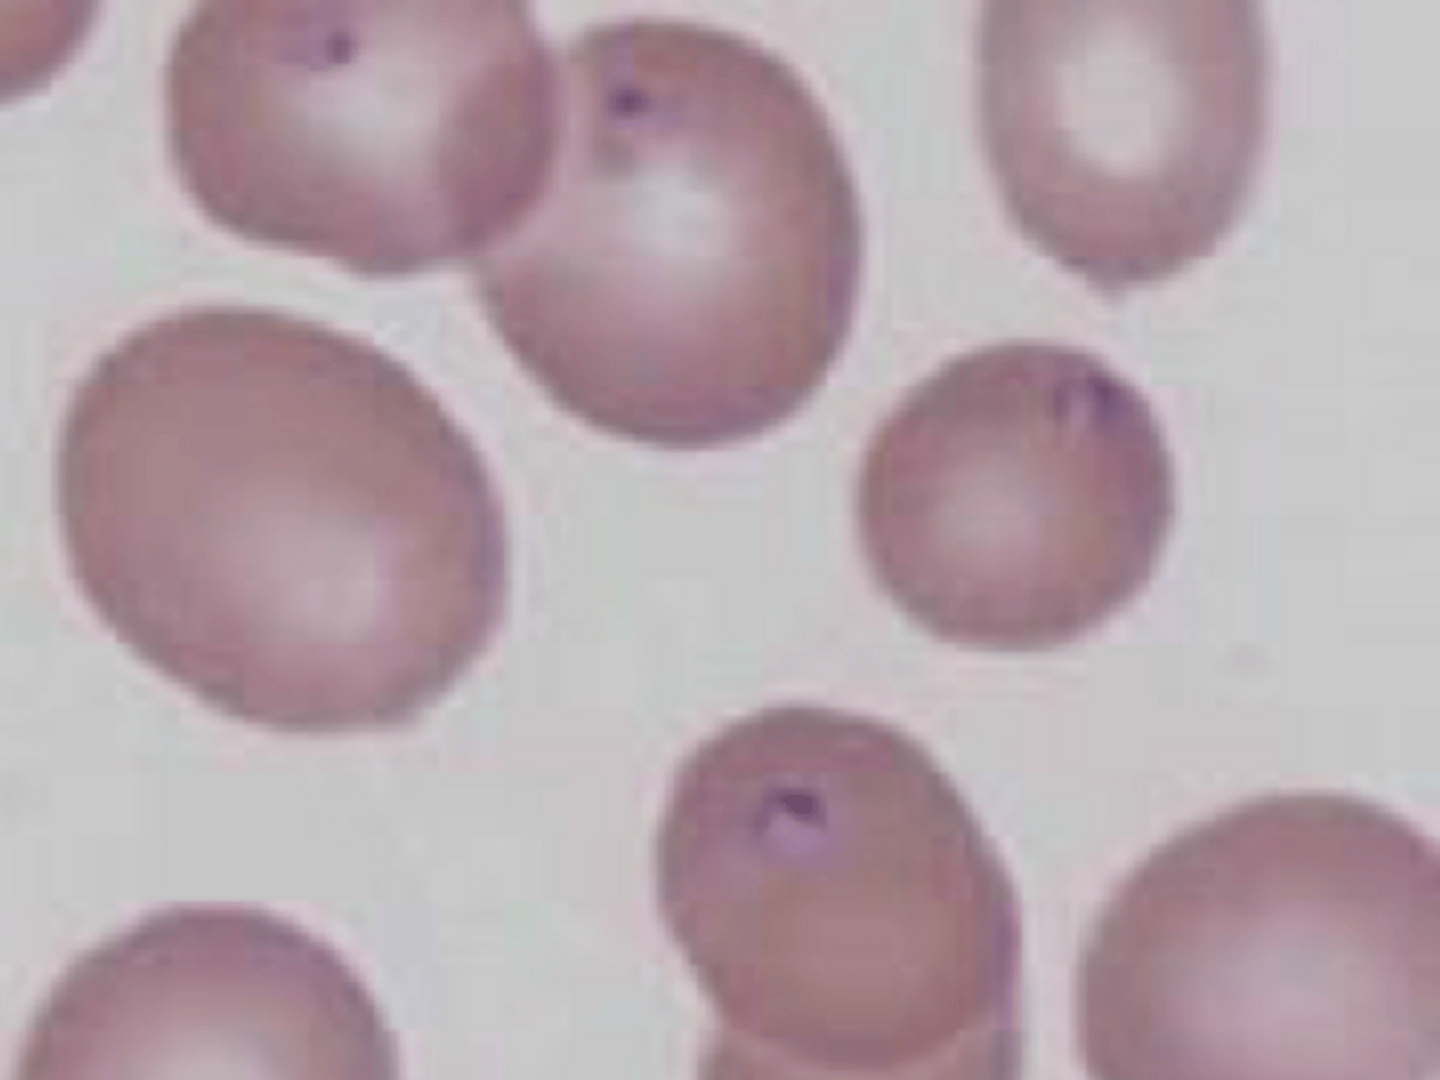
<p>What is the following parasite></p>

Regenerative Anemia
1/54
There's no tags or description
Looks like no tags are added yet.
Name | Mastery | Learn | Test | Matching | Spaced | Call with Kai |
|---|
No analytics yet
Send a link to your students to track their progress
55 Terms
What is used to dx anemia?
PCV/ HCT
Name some clinical signs of anemia?
Pale MM
Lethargy
Increased CRT
Tachycardia/pnea
Low grade arryrthmias
What are the three general causes of anemia?
Loss (regenerative to non-regenerative w/ time)
Destruction (Regen)
Decreased production (non-regen)
How is regenerative anemia characterized?
Reticulocytosis!!!!
-bonemarrow response
What are analyzer findings of Regenerative anemia?
High MCV - larger RBC
Decreased MCHC - decreased hemoglobin
What are blood smear findings regenerative anemia?
Moderate to marked:
Anisocytosis (Dif sizes)
Polychromasia (purple color change)
Basophilic stippling (in ruminants)
What is macrocytosis?
Increased MCV
What is Hypochromasia?
Decreased MCHC

What will you see in a canine and feline w/ regenerative anemia?
Released polychromatophils
What animal will not release polychromatophils
Horses

Which animal will have Basophilic stippling in regenerative anemia?
Cattle
What are characteristics of polychromatophils?
Larger (increased MCV)
Less hemoglobin (decreased MCHC)
Bluer - more retained proteins
What is Metarubericytosis?
Nucleated RBC - Typically seen as less than 1nRBC/100WBC
Metarubericytosis will NOT equal what?
Regeneration
nRBC and Leukocytes are often confused by the analyzers. What are ways to tell them apart on blood smear?
nRBC have red/purple cytoplasm, pyknotic nuclei, and irregular cell borders
What is appropriate Metarubricytosis?
Increased nRBC in circulation w/ evidence of regeneration (Reticulocyte presence)
Explain how Metarubricytosis occurs?
Bone marrow endothelium contracts to let reticulocytes out and some nRBC can slip out as well
What is a Howell jolly body?
Remains of the nucleus in the RBC
-Can be seen in regenerative anemia but not diagnostic
What is the MOA of Regenerative anemia?
Tissue hypoxia stimulates EPO production leading to reticulocytes being released
How long does it take for bone marrow to respond to anemia?
3-5 days
How do you calculate the absRet?
Reticulocyte % x RBV in the millions
-always need this # to dx regenerative anemia
What can we use to differentiate blood loss and hemolysis regenerative anemia?
Hypoproteneimia is associated with Blood loss
What will we see in Per-acute hemorrhage?
Normocytic/chromatic
Reticulocytes WNL
(Bone marrow hasn't had time to respond)
What will we see in acute hemorrhage?
3-5 days post insult
-Macrocytic (Increased MCV)
-Hypochromic (Decreased MCHC)
-Reticulocytes elevated
What will we see in chronic Hemorrhage?
Several days to weeks
-Depleted iron
-Micorcytic (Decreased MCV)
-Hypochromatic (Decreased MCHC)
-Reticulocytes WNL
Name a few causes of hemolysis?
IMHA
Oxidative damage
Infectious dz
RBC fragmentary inj
What are lab work signs of Extravascular hemolysis?
Hyperbilirubinemia
Bilirubinuria
(Icteric)
What are lab work signs of intravascular hemolysis?
Hemoglobinemia
Hemoglobinuria
(Red urine/ blood)
How does extravascular hemolysis work?
Antibodies mark RBC for splenic macrophage destruction - out of vasculature
How does intravascular hemolysis work?
Toxin/ oxidative damage or MAC complexes causing cell lysis in circulation
What are signs of oxidative intravascular hemolysis?
Heinz bodies
Eccentrocytes
What are signs of complement cascade intravascular hemolysis?
Ghost cells
What will we see in IMHA?
Mostly extravascular hemolysis in dogs (idiopathic)
What are analyzer findings for IMHA?
Macrocytic (Increased MCV)
Hypochromic (Decreased MCHC/ can be falsely normal LIAH)
Reticulocytosis
Inflammatory leukon
What are blood smear findings for IMHA?
Polychromasia
Spherocytes
Ghost cells
What are the following cells?
Spherocytes -only in dogs - smaller w/ no central pallor

How do you tell the difference between Rouleaux and agglutination?
Saline agglutination test
What are possible dx of IMHA?
CBC w/ Blood smear
Saline agglutination
Coombs test
Name a few hemolytic toxins?
Acetominaphen - cats
Red maple leaf - horses
Onion and garlic
Zinc
Copper - small ruminants
What will we see concurrently w/ zinc tox?
Acute hemolytic anemia
Concurrent pancreatitis
What will we see w/ viperine envenomation?
Cytotoxic and coagulopathic effects w/ some intravascular hemolysis
What will we see w/ elapidae envenomation?
Neurotoxic w/ intravascular hemolysis
What are causes of elevated Heinz bodies in cats?
DM
Lymphoma
Hyperthryroidism
Heinz bodies will not cause what?
Hemolytic crisis
Mycoplasma haemofelis will cause what?
Infect the surface of the RBC - Regenerative anemia hemolysis
What will Cytauxzoon felis cause?
Nonregenerative anemia hemolysis
How is Mycoplasma haemofelis spread?
Fleas - most common cause of hemolytic anemia in cats - good prognosis
How is Cytauxzoon felis spread?
Ticks - poor prognosis
What are clinical signs of Cytauxzoon felis ?
Thrombocytopenia
Leukopenia
What breeds are more likely to get Babesia canis?
Greyhounds
What is the following parasite?
Babesia canis
What is the following parasite>
Babesia gibsoni - pitbulls

What is Equine piroplasmosis
Theileria equi

What is the following parasite?
Anaplasma marginale - cattle most common
What is going to cause RBC fragmentation?
DIC
HF
Vasculitis
HW
Neoplasms